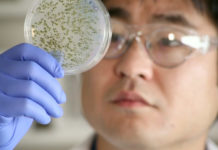
Scientist uses open-source techniques to turn bugs into patent-free drugs Scientist uses open-source techniques to turn bugs into patent-free drugs

BeBop Sensors unveils wearable smart fabric technology
Patented monolithic fabric sensor can measure all aspects of physicality, including force, location, size, twist, bend, stretch and motion.
Limeade secures $25M is Series C funding
The company plans to use the funds to expand its employee engagement platform and launch new products that meet the "evolving needs of employers."
Fitbit Charge, Charge HR and Surge officially announced
The most interesting of the pack, Fitbit Charge, will be available for $250, featuring a bright LCD screen and all sensors you would expect in a smart watch.
Scientist uses open-source techniques to turn bugs into patent-free drugs
Isaac Yonemoto's Project Marilyn is looking to raise $75,000 to use a compound sequenced from microscopic bug cultures to treat cancer.
Berg Insight: 13.7 million Europeans to use connected care solutions in 2019
The market is opening up to new types of solutions followed by next-generation telecare systems such as remote visits and video communication.
Sickweather gets an Android app
The application can alert users in real-time when they enter Sick Zones, which are areas where illnesses are reported on social media.
Google Fit vs. Apple HealthKit
The two of the largest tech companies each has a platform of its own to collect users' health and fitness data. Google Fit is available both on Android and iOS.
MTS Health Investors completes a majority investment in myNEXUS
myNEXUS' service acts as a link that connects many parts of the healthcare system including individuals, physicians, health providers and insurers.
Google Fit app is basic, feels like “work in progress”
The application allows users to track their activities either automatically or manually input the exercise type, duration and distance.
Phreesia raises $30M in a round led by LLR Partners
The company, which offers healthcare point-of-service platform solution, will use the money to accelerate product development and expand its customer base.